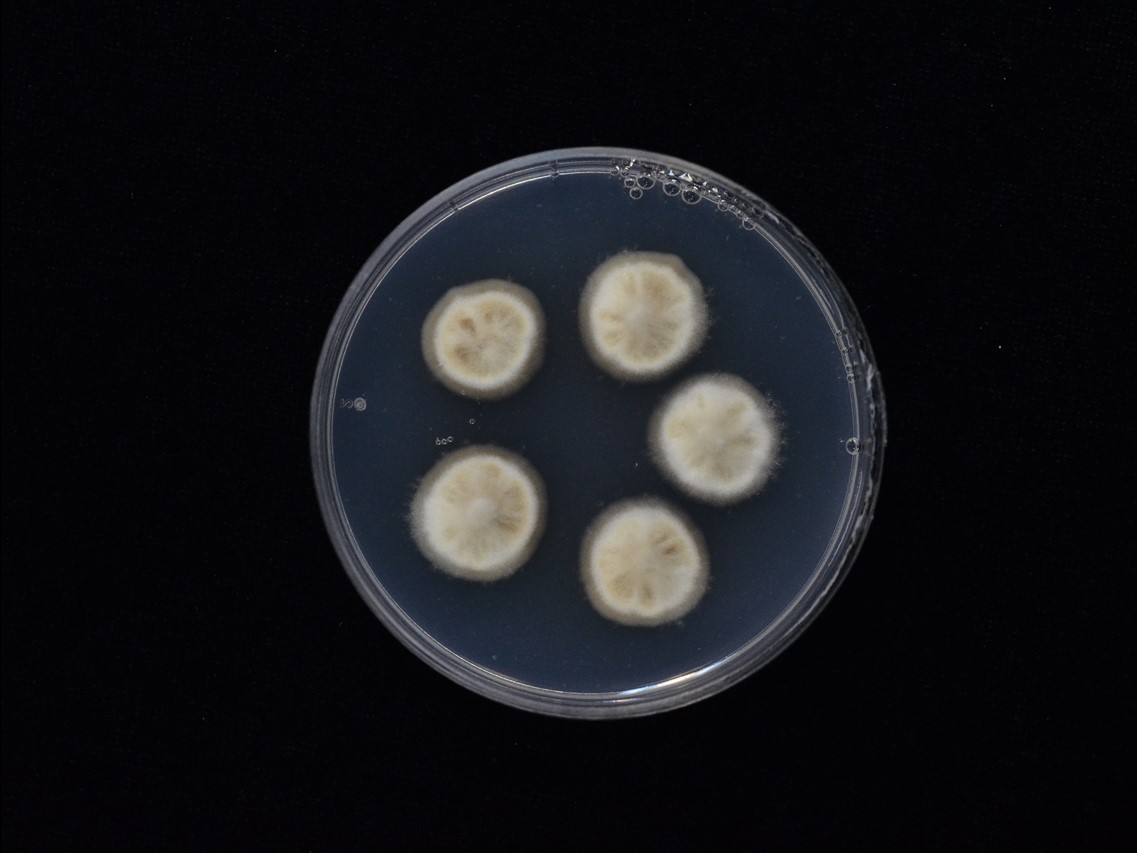

Holotype:
THAILAND, Nakhon Ratchasima Province, Khao Yai National Park, 18 Jun. 2009, K. Tasanathai, P. Srikitikulchai, S. Mongkolsamrit, T. Chohmee, R. Ridkaew, N.L. Hywel Jones, holotype BBH 26311, ex-type living culture BCC 36938.
Habitat:
Leaf litter.
Host:
Lepidoptera larva.
Description:
 Stromata solitary to several, cylindrical, branched, mostly erect, 50-100 mm long, 1-2 mm wide, yellow to brown with a sterile tip, arising from the larvae of Lepidoptera in the leaf litter (body size 40 × 7 mm).
Stromata solitary to several, cylindrical, branched, mostly erect, 50-100 mm long, 1-2 mm wide, yellow to brown with a sterile tip, arising from the larvae of Lepidoptera in the leaf litter (body size 40 × 7 mm).  Perithecia superficial, densely packed covering lower part to apex of stroma, ordinal in arrangement, subglobose to ovoid, 350-450 × 240-290 μm.
Perithecia superficial, densely packed covering lower part to apex of stroma, ordinal in arrangement, subglobose to ovoid, 350-450 × 240-290 μm.  Asci hyaline cylindrical, 8-spores, 175-230 × 5-7.5 μm.
Asci hyaline cylindrical, 8-spores, 175-230 × 5-7.5 μm.  Ascospores filiform, 180-200 × 2- 2.5 μm, remain whole after discharge, with septation.
Ascospores filiform, 180-200 × 2- 2.5 μm, remain whole after discharge, with septation.
Culture characteristics:
Colonies on PDA attaining a diam of 12–14 mm in 20 d at 20°C, funiculose, cream to brown bearing conidiogenous cells and conidia of the Hirsutella asexual morph, reverse dark brown. Conidiogenous cells mono or polyphialidic, arising from hyphae laterally or terminally, hyaline, cylindrical with tiny warts, 20–27 μm long, 3 μm wide at the base gradually tapering to a thin neck, 1 μm wide with twists in a helix at the apex. Conidia hyaline, 1-celled, smooth-walled, lemon-shaped to falcate, arising from the apex of the neck singly, 5–7 × 3–4 μm, embedded in a mucous sheath.
Colonies on PDA attaining a diam of 12–14 mm in 20 d at 20°C, funiculose, cream to brown bearing conidiogenous cells and conidia of the Hirsutella asexual morph, reverse dark brown. Conidiogenous cells mono or polyphialidic, arising from hyphae laterally or terminally, hyaline, cylindrical with tiny warts, 20–27 μm long, 3 μm wide at the base gradually tapering to a thin neck, 1 μm wide with twists in a helix at the apex. Conidia hyaline, 1-celled, smooth-walled, lemon-shaped to falcate, arising from the apex of the neck singly, 5–7 × 3–4 μm, embedded in a mucous sheath.
Reference:
Tasanathai K, Thanakitpipattana D, Himaman W, et al. (2020). Three new Ophiocordyceps species in the Ophiocordyceps pseudoacicularis species complex on Lepidoptera larvae in Southeast Asia. Mycological Progress 19: 1043–1056.
DOI: https://doi.org/10.1007/s11557-020-01611-6Species |
Strain |
Compound |
Pubchem CID |
Biological activity |
Reference |
|---|
|
Strain |
LSU | RPB1 | RPB2 | TEF1 |
|---|---|---|---|---|
| BCC 36938 | MT118175 | MT118183 | MT118188 | MT118167 |
| BCC 36940 | MT118176 | MT118189 | - | MT118168 |
| BCC 55764 | MT118177 | MT118182 | MT118190 | MT118169 |